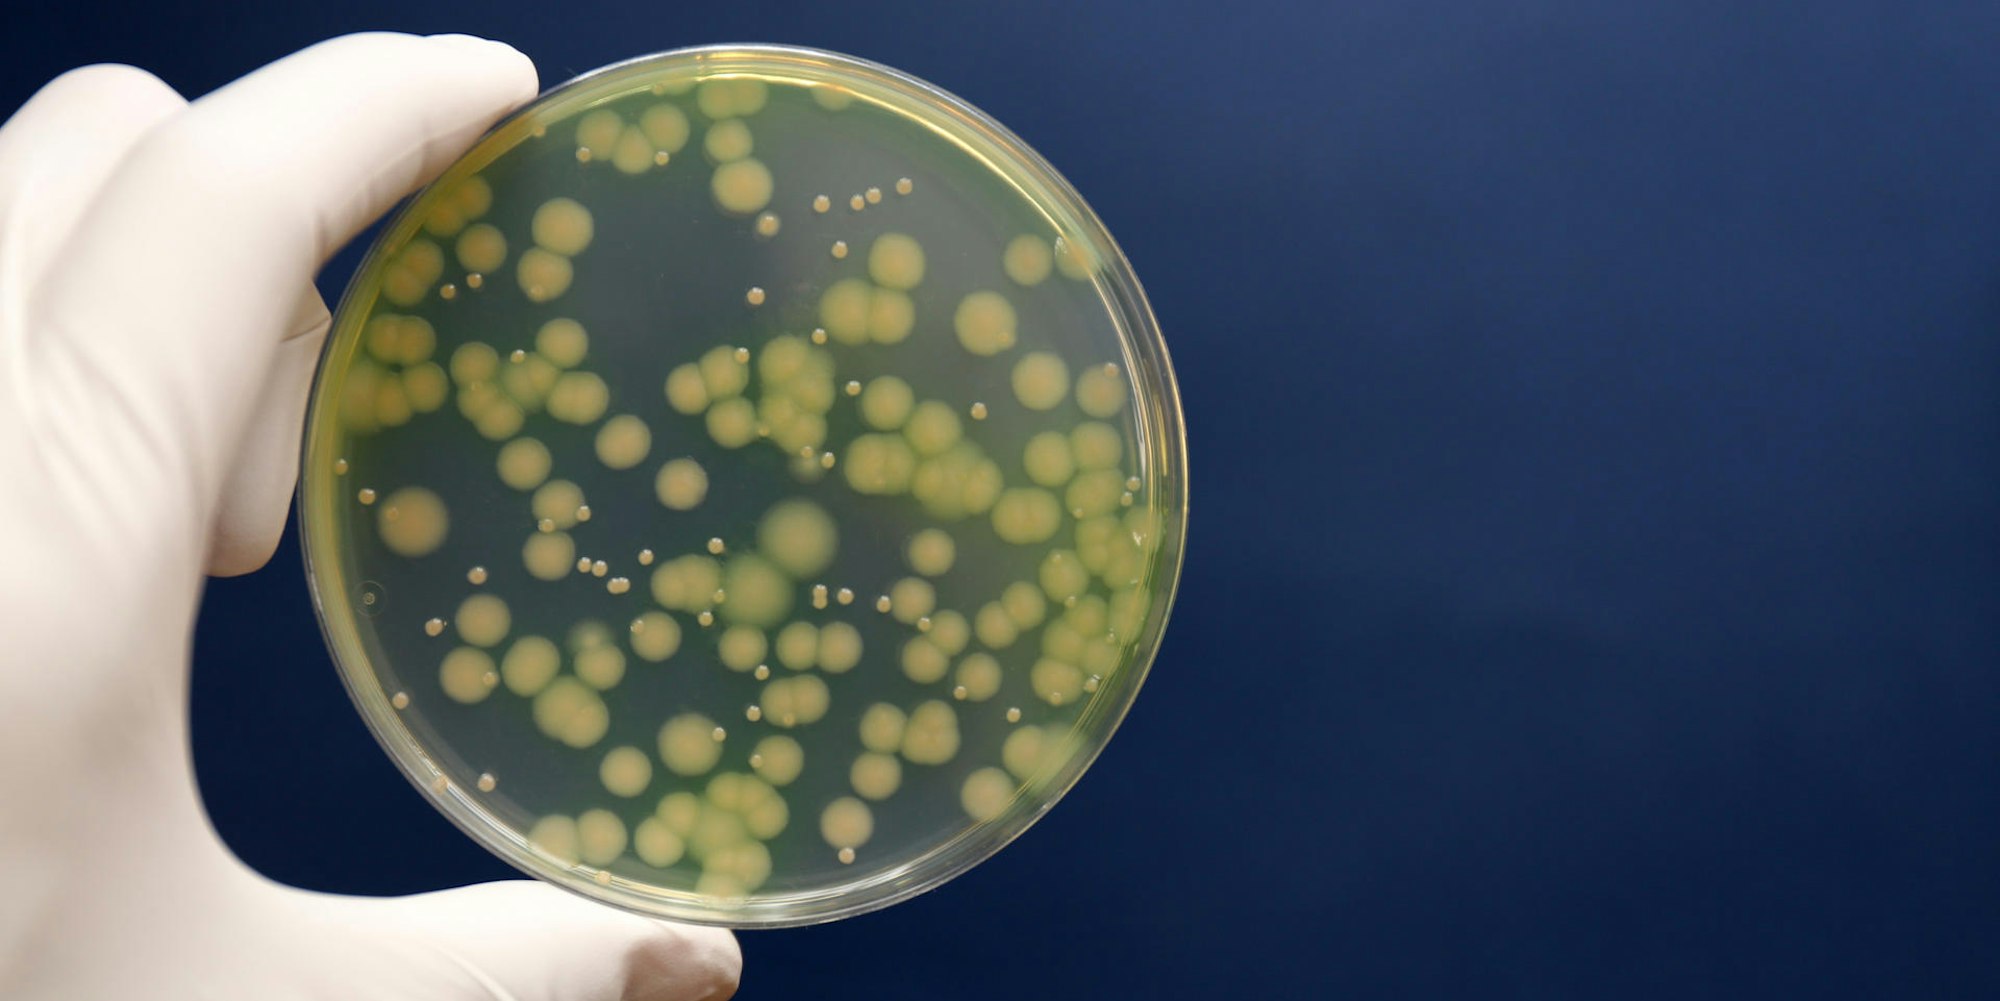
GettyImages-879088938

Keime in Kölner Praxis28 Patienten nach Spritze erkrankt – Todesfall wird untersucht
Mindestens 28 Menschen sollen sich mit den Keimen infiziert haben (Symbolbild).
Copyright: Getty Images/iStockphoto
Köln – In einer Kölner Radiologiepraxis in der Zeppelinstraße ist es zu einem schweren Ausbruch eines Keims gekommen. Bei Injektionen im Bereich der Wirbelsäule haben sich im Medizinischen Versorgungszentrum (MVZ) am Neumarkt etliche Patienten mit einem gefährlichen Bakterium angesteckt. „Im Rahmen von CT-gesteuerten periduralen Infiltrations-Therapien ist es in einem Zeitraum von zirka zweieinhalb Wochen zu Infektionen mit einem pansensiblen Erreger Pseudomonas aeruginosa gekommen“, bestätigte der ärztliche Geschäftsführer des MVZ, Michael Herbrik, auf Anfrage des „Kölner Stadt-Anzeiger“. 28 Patienten seien betroffen.
Ein 84-jähriger Kölner, der im Januar eine solche Spritze erhielt, ist gestorben, nachdem in der Folge der Behandlung schwere Komplikationen aufgetreten waren. „Als eine Querschnittslähmung drohte, musste mein Mann notoperiert werden“, sagt die Ehefrau. 36 Stunden nach der OP starb der Mann. Ob der Tod auf die Keiminfektion zurückzuführen ist, werde jetzt in einem „Todesermittlungsverfahren“ geklärt, teilte die Kölner Staatsanwaltschaft mit. Laut Obduktionsbericht starb der Patient an Multiorganversagen.
MVZ hat selbst die Staatsanwaltschaft eingeschaltet
Mehrere Patienten des Versorgungszentrums erlitten nach Informationen dieser Zeitung infolge der Behandlung eine lebensgefährliche Hirnhautentzündung (Meningitis). Die Deutsche Gesellschaft für Krankenhaushygiene spricht vom „schwersten Ausbruch mit diesem Erreger in einer ambulanten medizinischen Einrichtung überhaupt“. „In Europa ist bislang kein schwererer Fall beschrieben worden“, sagte Vorstandssprecher Peter Walger.
Pseudomonas aeruginosa
Die Weltgesundheitsorganisation WHO hält den Keim Pseudomonas aeruginosa für den gefährlichsten weltweit, was Antibiotikaresistenzen betrifft. Die Erforschung neuer Antibiotika müsse höchste Priorität haben, um eine Erhöhung von Todesfällen infolge von Infektionen zu verhindern. (uk)
Das MVZ, eine radiologische Praxis im Kölner Stadtzentrum, hat nach eigenen Angaben „aufgrund der Vielzahl der betroffenen Patienten“ selbst die Staatsanwaltschaft eingeschaltet. Laut Gesundheitsamt und betroffener Praxis ist die Ursache für den Ausbruch bislang nicht gefunden worden. Zwar sei im Waschbecken des Behandlungsraums das Bakterium Pseudomonas aeruginosa entdeckt worden, es handele sich jedoch nicht um den Erreger, der bei den Patienten festgestellt wurde, teilte MVZ-Geschäftsführer Herbrik mit. „Es ist aber für uns nicht anders erklärbar, als dass der Keim im Rahmen der Infiltrationstherapie in die Patienten gelangt ist.“ Das Operationsverfahren sei ausgesetzt worden.
Die Spritzen wurden durch einen Radiologen des MVZ sowie eigenverantwortlich von vier externen Orthopäden gesetzt. Im Zeitraum vom 2. Januar bis zum 1. März 2019 sind nach Angaben des Versorgungszentrums 297 Patienten mit der Therapie behandelt worden, einige von ihnen mehrfach. Da der Infektionszeitraum nicht sicher ist, seien die meisten potenziell Betroffenen Ende März schriftlich und mündlich informiert worden. „Wir stehen in engem Kontakt mit den betroffenen Patienten und bedauern sehr, dass sie sich in unserer Praxis infiziert haben“, so MVZ-Geschäftsführer Herbrik. Er kündigte zudem an: „Sofern unseren Patienten durch ein Verschulden der Praxis ein Schaden entstanden ist, werden wir für diesen einstehen.“
